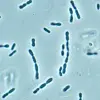

Ingen metan fra permafrost
Det var store utslipp av metan fra våtmarker og gasslekkasjer fra russiske gassfelt i 2008 og 2009, men det er foreløpig ingen klare tegn til økte utslipp fra tinende permafrost.
Denne artikkelen er over ti år gammel og kan inneholde utdatert informasjon.

Et forskerteam har ved hjelp av isotopanalyser av metan undersøkt årsaken til økningen i metankonsentrasjonene som er målt på Zeppelin-observatoriet i Ny-Ålesund på Svalbard.
Resultater fra 2008 og 2009 viser at det var særlig store utslipp av metan fra våtmarker og gasslekkasjer fra russiske gassfelt disse årene. Det er ingen indikasjoner på at utslipp fra hydrater på havbunnen når atmosfæren.
– Foreløpig ser vi heller ikke klare tegn til økte utslipp av metan fra tinende permafrost, sier seniorforsker Cathrine Lund Myhre fra NILU.
Studien er publisert i Geophysical Research Letters.
Bekymringsfulle metanøkninger
Etter CO2 er metan den viktigste bidragsyteren til menneskeskapt global oppvarming, og gassen har både menneskeskapte og naturlige utslippskilder.
Målinger som NILU har gjort ved sitt observatorium på Zeppelin ved Ny-Ålesund, har vist en stadig økning i metankonsentrasjonene de siste fem årene.
Dette har vært sammenfallende med metanøkninger som er målt både på andre stasjoner i Arktis, men også globalt sett. En er imidlertid særlig bekymret for endringer i de store potensielle metankildene i Arktis.
Det er enorme mengder karbon lagret i permafrost både på land og havbunn. Disse kildene kan slippe ut store mengder metan dersom permafrosten tiner.
– Da får vi en såkalt positiv feedback, eller tilbakekoblingsmekanisme forklarer Lund Myhre.
– Når permafrosten tiner, slippes det ut store mengder metan. Dette bidrar til økt oppvarming, og økt tining av permafrost, som igjen bidrar til ytterligere økning av metanutslippene.
Hvorfor øker metan i atmosfæren?

De siste årene er derfor forskningsaktiviteten rundt metan intensivert for å forstå endringene som påvirker nivået av gassen i atmosfæren:
– Det var en særlig stor økning i metan i 2007 og 2008. Isotopmålinger av metan på Zeppelin som vi har utført i samarbeid med Royal Holloway, University of London, viser at det var særlig stort bidrag fra utslipp fra Arktiske våtmarker i nord i Russland.
– Dette kan skyldes den spesielt varme sommeren i Arktis i 2007. I det hele tatt er våtmarker en hovedkilde til metanutslipp om sommeren, forklarer Lund Myhre.
Når det gjelder økningen som ble registrert våren 2009, har forskerne funnet ut at også gasslekkasjer fra gassrør kan forklare en del av dette.
– Det er bemerkelsesverdig at gassledninger er så lekk at det gir økning i regionale metankonsentrasjoner. Dette burde det være interesse for å redusere da det ikke er økonomisk lønnsomt med slike lekkasjer heller, sier Lund Myhre.
Forskerne var spesielt interessert i om de kunne se tegn til at det har vært utslipp fra metanhydrater som ligger lagret i store mengder på havbunnen nær Zeppelin og vest for Spitsbergen.
Det var kampanjer med skip for å undersøke dette samtidig som det ble gjort målinger på Zeppelin.
– Vi kan foreløpig ikke se noen tegn til at metanøkningen kommer fra denne kilden. Men dette kan endre seg, særlig i grunne havområder hvis temperaturen i Arktis fortsetter å øke sier Lund Myhre.
Metanhydrater er metan bundet til vann slik at de danner krystaller. Metan lekker fra disse hydratene, men foreløpig når ikke metan opp til havoverflaten og ut i atmosfæren i særlig grad. Imidlertid er dette temperaturavhengig:
Øker havtemperaturen, løses metanhydrater lettere opp i vann. Dette er en av bekymringene.
Det er også målt en økning i metankonsetrasjonen på den sørlige halvkule. Det antas at dette skyldes at tropiske våtmarker i Amazonas og Indonesia hadde større utslipp som en følge av endret og økt nedbør, og samt tropiske branner høsten 2006.
Komplisert målemetode

Forskningsteamet har benyttet såkalte isotopmålinger for å identifisere metankildene. Ulike metankilder har ulik sammensetning av 12C- og 13C-isotopene.
Dette benyttes sammen med modellering av lufttransporten til Zeppelin for å identifisere kilder og kildeområder. Metoden er spesielt utfordrende å benytte i Arktis, fordi kildene gir svake isotopsignaler.
– Dette krever høy presisjon fra både apparater og målemetodikk, sier Lund Myhre.
Isotoparbeidet og analysene er ledet av og utført ved Royal Holloway, University of London.
Mer metan
Mens NILUs målinger fra 1998 til 2005 viste relativt stabile konsentrasjoner, har det vært årlige økninger fra 2006 til 2009. Økningene er spesielt synlige høsten 2007 og senhøsten 2009.
26. desember 2009 ble det målt et nivå på 1975 ppb (parts per billion). Dette er det høyeste som noen gang er målt på Zeppelinobservatoriet. Andre episoder med svært høye verdier er senere blitt målt i perioden.
Det globale nivået nådde også ny rekord i 2009 med 1803 ppb, en økning på 5 ppb siden 2008.
Rundt 60 prosent av metanet i atmosfæren stammer i dag fra menneskeskapte kilder. De viktigste av disse kildene er jordbruk (drøvtyggere), rismarker, søppelfyllinger, kull, olje, gass og branner. De viktigst naturlige kildene er våtmarker, termitter, geologiske kilder, havet, ville dyr, branner.
Det er også store naturlige reservoarer av metan lagret i permafrosten, både på land og under hav. En økning av metan i atmosfæren kan enten skyldes en økning i utslipp fra en eller flere kilder, eller en endring i nedbrytningen.
Metan brytes stort sett ned i atmosfæren og har en levetid på ca 10 år. Det er forventet at mange av de naturlige kildene er påvirket av klimaendringer som endring i temperatur, særlig i Arktis, og endring i nedbør.
Bakgrunn:
Forskerteamet bak studien er et samarbeid mellom NILU og Universitetet i Tromsø fra Norge, universitetene i London, Southampton og Oxford i England samt Royal Netherlands Institute for Sea Research. R.E. Fisher og E. Nisbet fra Royal Holloway,University of London har ledet prosjektet.
Prosjektet har vært støttet av Natural Environment Research Council som del av deres bidrag i det Internasjonale polaråret, samt støtte fra Royal Holloway. EU har også bidratt med støtte bl.a. fra GEOMON-programmet.
Referanse:
Fisher m.fl.: Arctic methane sources: Isotopic evidence for atmospheric inputs, Geophysical Research Letters, VOL. 38 2011, L21803, 6 PP., doi:10.1029/2011GL049319.